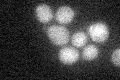
YOR338W
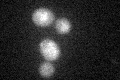
YOR338W
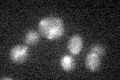
YOR338W

View description
Putative protein of unknown function; YOR338W transcription is regulated by Azf1p and its transcript is a specific target of the G protein effector Scp160p; identified as being required for sporulation in a high-throughput mutant screen
Localization:
Intensity:
Fold change:
Significance:
-
C’ GFP library in SD
below threshold16.06 -
N' NOP1pr-GFP in SD

N/A0 -
N' TEF2pr-mCherry in SD

N/A0 -
N' NATIVEpr-GFP in SD

N/A0 -
N' TEF2pr-VC and Cyto-VN in SD

N/A0 -
C’ GFP library in SD+DTT
cytosol15.160.94No -
C’ GFP library in SD+H2O2
cytosol20.921.3No -
C’ GFP library in Starvation Media

cytosol26.681.66No -
C’ GFP library on the background of Pup2-DaMP

below threshold -
C’ GFP library on the background of CCT mutant

below threshold16.77181.04386No
